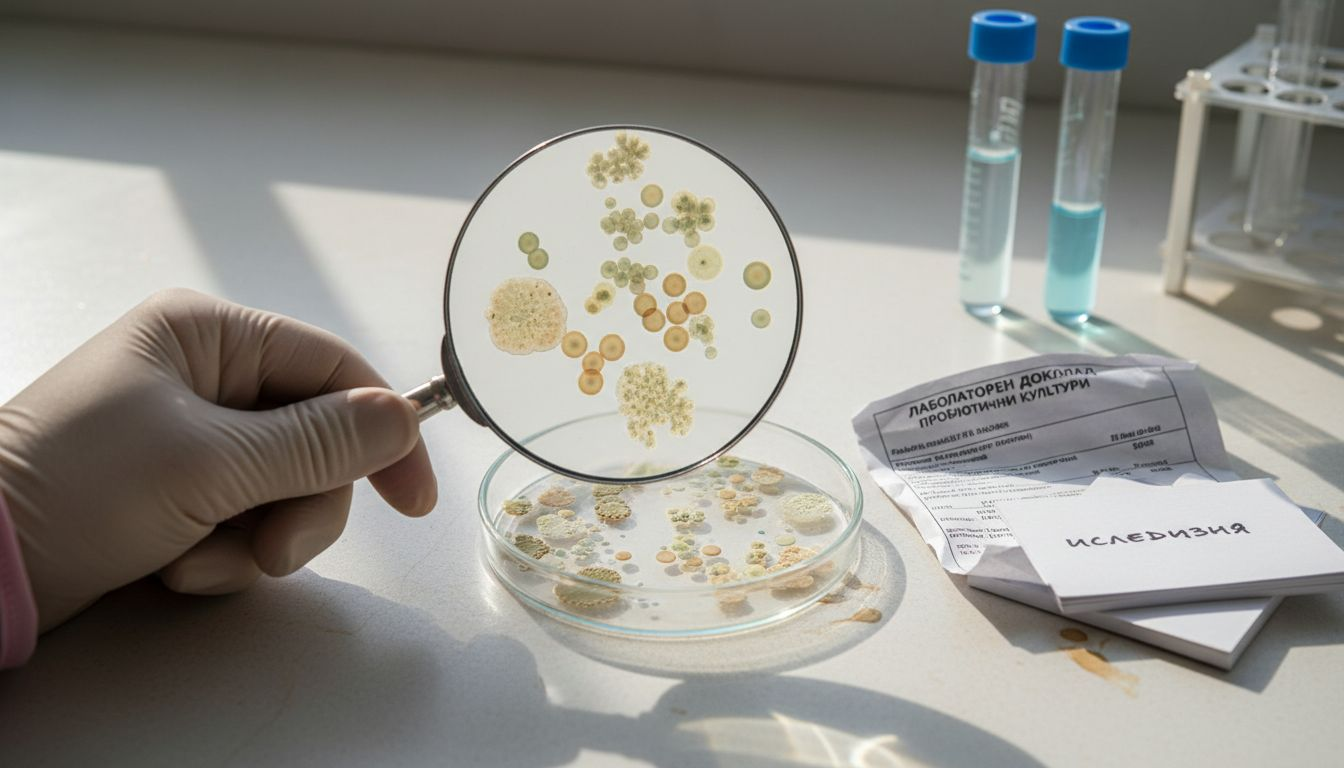
Петри с развиващи се колонии от пробиотични бактерии

Изборът на пробиотичен щам за женското здраве не е лесна задача, когато здравето и балансът на организма са приоритет. Все повече жени в Централна Европа търсят доказани решения за подкрепа на хормоналния баланс и добро храносмилане, а разпространените митове могат да объркат дори най-информирания избор. Научната селекция на щамовете и разбирането на истинските ползи от конкретните пробиотични микроорганизми са основата за съзнателен и отговорен подход към здравето.
Съдържание
- Пробиотичен щам – определение и митове
- Основни видове пробиотични щамове
- Характеристики и действие на пробиотиците
- Избор на щам за хормонален баланс
- Рискове и чести грешки при приема
Основни изводи
| Точка | Детайли |
|---|---|
| Пробиотиците са разнообразни | Не всички пробиотични щамове действат еднакво и изборът трябва да е персонализиран. |
| Консултация с експерт | Преди избор на пробиотик е важно да се консултирате със специалист за най-подходящия щам. |
| Правилен прием | Следвайте указанията за дозиране и не прекъсвайте приема веднага, за да избегнете нежелани ефекти. |
| Индивидуални реакции | Различия в индивидуалната микрофлора влияят на ефективността на пробиотиците, затова наблюдавайте реакциите на организма. |
Пробиотичен щам – определение и митове
Пробиотичните щамове са специфични микроорганизми с изключително важно значение за човешкото здраве, особено за женския организъм. Научните изследвания от Софийския университет подчертават, че не всички щамове са еднакви – те се различават по своите биологични характеристики и потенциал.
Основни характеристики на пробиотичните щамове включват:
- Устойчивост на стомашната киселинност
- Способност да преминават през гастроинтестиналния тракт
- Имуномодулиращо действие
- Способност за колонизиране на чревната микрофлора
Съществуват няколко разпространени мита за пробиотичните щамове, които е важно да бъдат разбити:
- Мит: Всички пробиотици са еднакви
- Мит: Повече пробиотици означава по-добре
- Мит: Пробиотиците работят еднакво при всички хора
Всъщност, научната селекция на щамовете изисква прецизен подход. Не всеки щам от рода Lactobacillus може да се счита за пробиотичен – необходими са детайлни молекулярни и класически методи за тяхната идентификация и характеристика.
Важно е да се знае, че пробиотичните щамове са специфични живи микроорганизми с доказан здравословен ефект.
При избора на пробиотик жените трябва да обръщат внимание на:
- Конкретния щам
- Неговата концентрация
- Доказани клинични изследвания
- Произход и качество
Професионален съвет: Консултирайте се с лекар преди да изберете конкретен пробиотичен щам, който отговаря на вашите индивидуални здравословни нужди.
Основни видове пробиотични щамове
Пробиотичните щамове се различават по своите биологични характеристики и специфични ползи за женското здраве. Щамовете Lactobacillus и Bifidobacterium са най-разпространените и добре проучени пробиотични микроорганизми, които играят ключова роля във вагиналната и чревната микрофлора.
Най-важните видове пробиотични щамове включват:
- Lactobacillus rhamnosus GG: Подкрепя имунната система
- Lactobacillus acidophilus: Подобрява храносмилането
- Bifidobacterium bifidum: Намалява възпалителните процеси
- Lactobacillus plantarum: Защитава от патогенни бактерии
- Lactobacillus reuteri: Регулира вагиналния pH
При женското здраве различните щамове имат специфични функции:
Ето как най-подходящите пробиотични щамове се отличават по действие за женското здраве:
| Щам | Основно физиологично действие | Подкрепа за хормонален баланс |
|---|---|---|
| Lactobacillus rhamnosus GG | Подсилва имунитета и намалява възпалението | Подобрява метаболизма на естрогени |
| Lactobacillus acidophilus | Подобрява храносмилането, стабилност на микрофлората | Поддържа балансиран хормонален фон |
| Bifidobacterium bifidum | Намалява възпалителните процеси | Спомага за по-добро детоксикиране |
| Lactobacillus plantarum | Защитава от патогенни микроорганизми | Влияе положително на вагиналното pH |
- Поддържане на вагинално pH
- Превенция на възпалителни инфекции
- Укрепване на имунитета
- Регулиране на хормоналния баланс
Всеки пробиотичен щам има уникални характеристики, които го правят различен от останалите.
Не всички щамове действат еднакво при всички жени. Индивидуалната микрофлора определя как конкретен щам ще повлияе на организма. Затова е важно да се избира щам, съобразен с индивидуалните здравословни нужди.
Професионален съвет: Консултирайте се с гинеколог или специалист по микробиология, за да определите най-подходящия пробиотичен щам за вашето здраве.
Характеристики и действие на пробиотиците
Пробиотиците са живи микроорганизми, които при правилен прием могат да окажат изключително благоприятно въздействие върху женския организъм. Функционалните характеристики на пробиотиците включват множество физиологични механизми, които подпомагат цялостното здраве.
Основни действия на пробиотиците:
- Възстановяване на чревната микрофлора
- Подсилване на имунната система
- Регулиране на метаболитните процеси
- Потискане на патогенни микроорганизми
- Намаляване на възпалителните реакции
Най-важните физиологични ефекти включват:
- Подобряване на храносмилателния тракт
- Укрепване на имунитета
- Балансиране на хормоналната система
- Редуциране на възпалителни процеси
Пробиотиците действат като естествена защитна система на организма, възстановявайки микробиалния баланс.
Микробиалното равновесие е от изключителна важност за женското репродуктивно и общо здраве. Различните щамове имат специфични функции – някои подобряват храносмилането, други укрепват имунитета, трети регулират хормоналния баланс.
Професионален съвет: Приемайте пробиотици редовно и консистентно, като спазвате препоръчителната дневна доза за максимален ефект.
Избор на щам за хормонален баланс
Изборът на подходящ пробиотичен щам за хормонален баланс е изключително индивидуален процес, който изисква разбиране на специфичните характеристики на щамовете. Женските хормонални процеси са комплексни и се нуждаят от прецизен подход при подбора на пробиотици.
Ключови критерии при избора на пробиотичен щам:
- Клинично доказан ефект върху хормоналния баланс
- Способност за влияние върху метаболизма на естрогените
- Подкрепа на вагиналната микрофлора
- Противовъзпалително действие
- Подобряване на чревния микробиом
Препоръчителни щамове за хормонален баланс:
- Lactobacillus rhamnosus GG
- Lactobacillus acidophilus
- Bifidobacterium bifidum
- Lactobacillus plantarum
Всеки пробиотичен щам има уникален профил на въздействие върху женския организъм.
Не всички щамове действат еднакво при различните жени. Факторите като възраст, хранителен режим, стрес и общо здравословно състояние играят съществена роля в ефективността на пробиотика.
Професионален съвет: Консултирайте се с гинеколог или специалист по микробиология, който може да препоръча най-подходящия пробиотичен щам според вашите индивидуални здравословни нужди.
Рискове и чести грешки при приема
Приемът на пробиотици крие определени рискове, които всяка жена трябва да познава и разбира. Неправилната употреба може да доведе до нежелани странични ефекти и загуба на очакваните ползи за здравето.
Най-чести грешки при приема на пробиотици:
- Неправилно съхранение на пробиотичния препарат
- Прием без консултация с медицински специалист
- Прекалено висока или ниска дневна доза
- Очакване на незабавни резултати
- Прекъсване на приема без постепенно адаптиране
Потенциални рискове включват:
- Стомашно-чревен дискомфорт
- Алергични реакции
- Взаимодействие с други медикаменти
- Временно нарушаване на чревната микрофлора
- Риск от инфекции при отслабен имунитет
Индивидуалната поносимост към пробиотичните щамове е различна и зависи от множество фактори.
Предупредителни сигнали, които изискват незабавно преустановяване на приема:
Сравнение на възможните странични ефекти и препоръчителни действия при прием на пробиотици:
| Потенциален страничен ефект | Причина | Препоръчано действие |
|---|---|---|
| Стомашно-чревен дискомфорт | Прекалено висока доза | Намалете дозата, консултация с лекар |
| Алергична реакция | Чувствителност към компонент | Преустановете приема, потърсете помощ |
| Взаимодействие с лекарства | Едновременно приемане с медикаменти | Консултирайте се със специалист |
| Временно нарушена микрофлора | Прекъсване на пробиотика | Възстановяване с адаптация и наблюдение |
- Силни стомашни болки
- Подуване и газове
- Диария
- Кожни обриви
- Температура
Професионален съвет: Започвайте с ниски дози пробиотици и постепенно увеличавайте приема, като внимателно наблюдавате реакцията на вашия организъм.
Открий тайната на здравето с правилния пробиотичен щам
Подкрепата на женското здраве изисква внимателен избор на пробиотици, съобразени с индивидуалните нужди и спецификата на хормоналния баланс. Край на объркването около неподходящите щамове и преминаване към ефективни решения, които действително подпомагат имунната система, регулират вагиналното pH и балансират хормоналния фон.

Разгледайте внимателно подбраните пробиотични продукти в онлайн магазина на VitaminsFlow, където ще намерите висококачествени пробиотици с доказан клиничен ефект. Възползвайте се от специалните предложения с актуални промоции и безплатна доставка за поръчки над определена сума. Не губете време и започнете промяната още сега с помощта на професионалните съвети и продукти на VitaminsFlow, които гарантирано ще подкрепят вашето здраве и красота.
Често задавани въпроси
Какви са основните ползи от пробиотичните щамове за женското здраве?
Пробиотичните щамове имат множество ползи, включително подобряване на храносмилането, укрепване на имунната система, поддържане на вагинално pH и регулиране на хормоналния баланс.
Как да избера подходящ пробиотичен щам?
При избора на пробиотичен щам е важно да се съобразите с конкретния щам, неговата концентрация, клинични изследвания и индивидуалните здравословни нужди.
Какви рискове има при приема на пробиотици?
Неправилната употреба на пробиотици може да доведе до стомашно-чревен дискомфорт, алергични реакции и взаимодействия с други медикаменти. Препоръчва се консултация с медицински специалист.

Как действат пробиотиците на хормоналния баланс?
Пробиотиците, като Lactobacillus rhamnosus GG, могат да подобрят метаболизма на естрогените и да подкрепят вагиналната микрофлора, което е от съществено значение за хормоналния баланс.